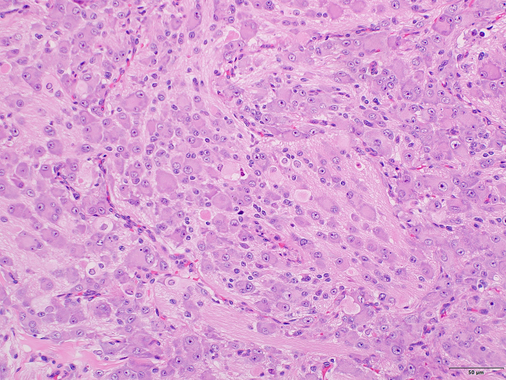

Name this tumour.
Line of differentiation?
Site predilection?
Explain appearance of cytoplasm?
Stains:
Describe any genetic exceptions

Granular cell tumour
Neuroectodermal differentiation
Predilection for the tongue
Granular cytoplasm caused by inactivating mutations in ATP6AP1 or 2 (so can’t break down lysosomes) -> granular ppearance.
Stains: S100 (+), CD68, inhibin, calretinin.
Genetic exceptions: congenital (ginival) granular cell tumour (congenital epulis) - looks simlar, located on gingiva at birth, S100-
Molecular mutation in myxoid liposarcoma:
FUS-DDIT3 t(12;16) OR
EWSR-DDIT3 t(12;22)
FUS rearrangements seen in which soft tissue tumours?
myxoid lipoidsarcoma
Low-grade fibromyxosarcoma
Angiomatoid fibrous histiocytoma
name the 4 types of Kaposi sarcoma
Causative agent?
Associations
1) classic (older males 90%; indolent)
2) Endemic/African (NOT a/w HIV, aggressive)
3) Iatrogenic (usu immunosuppressed; variable behaviour)
4) Aids-associated (coinfection with HIV and HHV8; most aggressive type)
HHV-8
Classic often a/w underlying malignancy (haematologic)
Kaposi sarcoma
What are the three stages of the disease?
- Patch stage
- Plaque stage
- Tumor stage
Kaposi sarcoma
Patch stage, key histological features?
Increased “jagged” interconnected vascular channels in reticular dermis
Dissecting/wrapping around collagen bundles
Growing around adnexa
Growing into normal vessels (promontory sign is characteristic but uncommon finding)
Lined by uniform endothelial cells with minimal atypia
Scattered plasma cells (very useful clue) and lymphocytes
Extravasated erythrocytes and hemosiderin deposits
Kaposi sarcoma
Plaque stage, key histological features
More extensive vascular proliferation
Increased inflammatory infiltrate with plasma cells
Spindle cell proliferation infiltrating dermis and invading/destroying eccrine glands
Kaposi sarcoma
Tumour stage, key histological features
Nodules of spindle cells arranged in intersecting fascicles
Blood-filled slit- and sieve-like spaces between spindle cells
When blood-filled spaces absent, may be difficult to recognize as vascular tumor
Mitoses often prominent, but nuclear atypia is usually only mild to moderate
If severe atypia, consider spindled angiosarcoma
In AIDS, KS may have more atypical areas similar to angiosarcoma
Intracytoplasmic hyaline globules in spindle cells
Some suggest these are degenerated erythrocytes
Inflammatory infiltrate with plasma cells usually present
IHC kaposi sarcoma
CD31, CD34, ERG, D2-D40 positive.
HHV-8 Punctate, speckled, or granular pattern of nuclear staining is classic. All other vascular tumours negative for HHV-8
DDx Kaposi sarcoma
Angiosarcoma: different clinical context, HHV-8(-)
Acroangiodermatitis (i.e. venous stasis): Dermal spindle cells are fibroblasts (not spindled endothelial cells as in KS) so negative for vasc markers.
Painful, well circumscirbed skin lesion. Higher power magnification:
Dx:
Key histological features:

Angioleiomyoma
Well-circumscribed tumour.
Bundles of cytologically bland smooth muscle cells growing concentrically around blood vessels of varying calibre.

angioleiomyoma
Subtypes (3)
Three subtypes of angioleiomyoma have been described based on predominant vascular morphology; solid, venous and cavernous.
The solid subtype is composed of compact bundles of smooth muscle surrounding compressed, slit-like vessels.
Venous subtype tumours are made up of thick-walled vessels with smooth muscle from blood vessel walls blending with intervascular smooth muscle bundles.
Cavernous subtype lesions are composed of dilated vascular channels with a proliferation of smooth muscle within intervascular spaces.
IgG4 related disease
Histologically, what features are highly suggestive of the disease?
2 out of 3…
1) Dense lymphoplasmacytic infiltrate
2) Fibrosis, usually storiform in character
3) Obliterative phlebitis
AND
> 40% IgG4/IgG plasma cell ratio IgG4+ plasma cells/high power field > 30 in surgical specimen or > 10 in biopsy specimen
Synovial sarcoma
IHC
Key molecular alterations
TLE1(+; 80-90%, specific + sens)
Cytokeratins: ~90% (depending on epithelial vs spindled component. CK7 ~(+) for both)
EMA: 29-90% +, variable
BCL2: 29-90% +
CD99(+): 91%
CD56(+) 100%
Molecular: t(X;18)(p11.2;q11): SYT-SSX1 fusion in 90% can detect via RT-PCR
Paediatric small round blue cell tumours
DDx?
IHC to distinguish them:
Neuroblastoma
Rhabdomyosarcoma
Ewing sarcoma
Lymphoblastic lymphoma
WT
Malignant rhabdoid tumour
IHC: PHOX2B, desmin, myogenin, MyoD1, CD99, NKX2.2, CD45, TdT, INI1, WT1

Rhabdomyosarcoma
What is myogenin?
Discuss myogenin staining in alveolar vs embryonal subtypes:
A transcriptional regulatory protein expressed early in skeletal muscle differentiation (therefore nuclear).*
ERMS is patchy
ARMS is diffuse (nuclear) staining
*Positive normal staining in fetal muscle, negative in adult muscle
What is MyoD1?
What does it stand for?
MYOD1 encodes a nuclear protein that promotes transcription of muscle specific target genes and regulates muscle cell differentiation.
myogenic differentiation 1 gene
More intense staining in ARMS than in ERMS
Excision foot
Dx?
Key features?

Traumatic (Morton’s) neuroma
Perineural, epineural, endoneural fibrosis, hyalinisation, fibrosis and thickening of vessel walls, fibrosis within adipose tissue.
37F thigh lesion
Dx?
IHC?

Desmoid fibromatosis
Essential: long, sweeping fascicles of bland fibroblasts and myofibroblasts without substantial cytological atypia; infiltrative growth.
Desirable: nuclear β-catenin expression; characteristic CTNNB1 mutation (in challenging cases or small biopsies).
SFT
Genetic mutation?
paracentric inversion involving chromosome 12q, resulting in the fusion of the NAB2 and STAT6 genes
SFT
Sub-types
IHC
Fat-forming; giant-cell rich; dedifferentiated
IHC: CD34(+); STAT6 nuclear (+)
Dx:
Essential and desireable dx features:

SFT
Essential: spindled to ovoid cells arranged around a branching and hyalinized vasculature; variable stromal collagen deposition; CD34 and/or STAT6 expression by immunohistochemistry.
Desirable (in selected cases): demonstration of NAB2-STAT6 gene fusion.
Below: Tumour cells typically display scant to moderate amounts of indistinct, palely eosinophilic cytoplasm and bland nuclei with fine pale chromatin and inconspicuous nucleoli.
DFSP
Molecular/genetic alteration?
COL1A1::PDGFB [t(17;22)(q21.33;q13.1)} fusion
34M slow growing thigh mass
Dx?
IHC:
Molecular:
Px:

Low-grade fibromyxoid sarcoma
Low to moderately cellular, bland fusiform or spindled cells with focal to diffuse whirling in heavily collagenized stroma with abrupt transition to myxoid areas
45% have epithelioid areas
40% contain poorly formed but large collagen rosettes
Often infiltrates adjacent skeletal muscle
Occasionally has areas of increased cellularity, atypia, necrosis or mitotic activity characteristic of intermediate to high grade sarcoma
IHC: MUC4(+) highly sensitive (100%) and specific; CD99 (+)(90%) and BCL2(+) (90%)
CD34(-) c.f. intramuscular myxoma (which also MUC4(-))
Molecular: t(7;16)(q32-34;p11) FUS-CREB3L2 fusion in 90% or more
DDx: Intramuscular myxoma; myxofibrosarcoma (more pleomorphism/hyperchromasia and more developed vasc network); desmoid type fibromatosis (lacks myxoid areas); myxoid neurofibroma (wavy nuclei, thick collagen bundles in b/g)
px: requires long-term f/u as can metastasise years later
Image: abrupt transition to myxoid area

































































